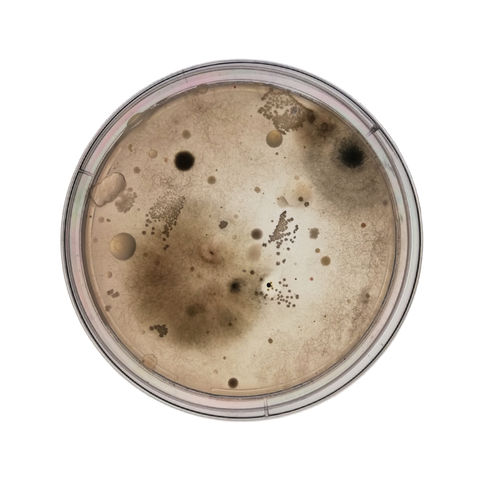
Agar_Art_Retakes 2 copy.jpg

top of page

Escarpment track, 2023
Stream 7 km from Pukerua Bay, Kapati Coast, NZ
pH 8.0
pH 8.0

Where the wild things are, 2022
Kirikiriroa Stream, Hamilton, NZ
pH 8.0
Collaboration with Kesia Kurian
pH 8.0
Collaboration with Kesia Kurian
Now I gotta resurface, 2022
Kirikiriroa Stream, Hamilton, NZ
pH 8.0
Collaboration with Kesia Kurian
pH 8.0
Collaboration with Kesia Kurian

Shalloween, 2022
Whairepo lagoon, Wellington, NZ
pH 8.0
pH 8.0

Eruption, 2022
Whairepo lagoon, Wellington, NZ
pH 8.0
pH 8.0

Watercolour palette, 2022
Indoor flat air and homemade agar.

Rise and shine, 2022
Mouth swab and homemade agar.

Mysterious microbes, 2020
Laboratory experiment gone wrong.
Contaminated LB agar.
Contaminated LB agar.

Ride the waves, 2021
Blue-white screen assay to select for bacteria containing recombinant plasmid.
Bacteria, recombinant and non-recombinant plasmids, antibiotic, X-Gal, IPTG LB agar.
Bacteria, recombinant and non-recombinant plasmids, antibiotic, X-Gal, IPTG LB agar.

Bacterial swim agar, 2020
Bacterial chemotaxis soft-agar swim plate assay.
Psa and tryptone agar.
Psa and tryptone agar.

Pancake, 2021
Collaboration with Dr Sarah Andreassend.
Unknown fungus and V8 juice agar.
Unknown fungus and V8 juice agar.

Neurons, 2021
Collaboration with Dr Mike Fairhurst.
Contaminated corn meal agar.
Contaminated corn meal agar.

Winter's butterfly, 2021
Collaboration with Sam Rhodda.
Dessicated LB agar.
Dessicated LB agar.

Snowflake angel, 2021
Collaboration with Dr Jordan Compton.
Dessicated LB agar.
Dessicated LB agar.

Pseudomonas syringae pv. actinidiae (Psa) colonies, 2020
Psa forms 1 mm, pale yellow-white, slightly raised, glistening, round colonies.
Psa and LB agar.
Psa and LB agar.

Organic crepe, 2021
Collaboration with Dr Mike Fairhurst.
Roots and filter paper.
Roots and filter paper.

Blood supermoon, 2021
Collaboration with Dr Josie Mainwaring.
Cellulase, congo red and carboxymethylcellulose agar.
Cellulase, congo red and carboxymethylcellulose agar.

Mars, 2021
Collaboration with Dr Sarah Andreassend.
Unknown fungus.
Unknown fungus.

Gold medal grandiflora roses, 2021
Collaboration with Dr Sarah Andreassend.
Unknown fungus.
Unknown fungus.
*Microorganism species should be italised - Wix gallery does not have this feature*
bottom of page